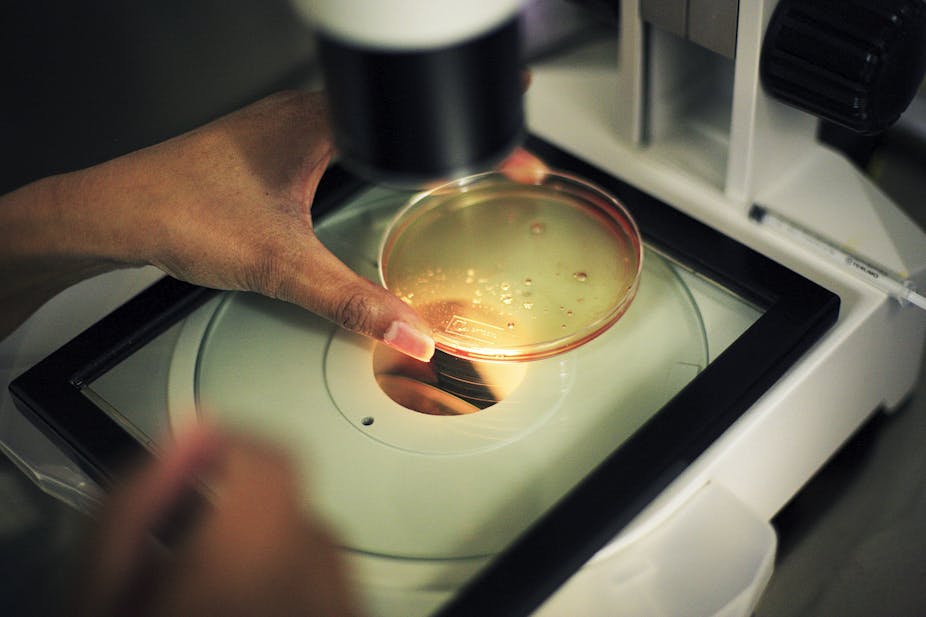

Women are 49.6% of the world’s population. An estimated 70% of the health and social care workforce are women; they deliver care to around 5 billion people. Women are also at the front-line of the battle against the COVID-19 pandemic – as health care givers, researchers, scientists and policymakers.
There is a well recognised gender disparity in science, technology, engineering and mathematics. This prompted the Alliance for Accelerating Excellence in Science in Africa) to conduct a study on factors contributing to or inhibiting women’s careers in these key fields in Africa.
The study highlighted the numerous factors that contribute to or hinder women’s success in these fields. It also explored how these reinforce each other. Understanding what these factors are, and how they operate, is vital to devising the multi-pronged approach that’s necessary for tackling these challenges.
This is the first review of its kind that gives an African perspective of the challenges that women in these fields face. They are by no means unique to Africa. What we do find significant is the stronger influence in Africa of role models, mentoring and family support in moving women along the trajectory of a career in science, technology, engineering and mathematics.
The study
Our study targeted research institutions within Africa’s eight regional economic communities recognised by the African Union. Particular focus was placed on institutions that the African Academy of Sciences works with and their networks with other programmes that support women in research. Respondents included women working in or studying science, technology, engineering and mathematics. Policy experts in Africa were also included.
Over 1200 emails were sent out to several institutions and 415 women scientists registered for the online survey. Of these, 396 (95.4%) completed the questionnaire that identified factors contributing to or inhibiting women’s careers in science, technology, engineering and mathematics in Africa. It specifically identified the challenges and opportunities that respondents face or have faced in their own careers. A face-to-face validation workshop was held with a subset of women scientists.
The study showed that women’s success in these key fields was influenced by individual, family, societal and work environment factors. These included personal capabilities and academic preparation. Access to funding and having women role models also emerged as factors. Patriarchal attitudes at a macro level were most significant. For women already working in these areas, the work environment and recruitment process, promotion and gender relations were major influences. Policies to address the gender gap were reported to exist but rarely implemented.
Findings
Our study found that seeing other women working in these fields was a significant factor in influencing their choice to be in science, technology, engineering and mathematics. Girls from families with women professionals were motivated to follow their lead. Other successful women scientists also acted as role models for younger women.
We found that 78% of women had family support, 7% of families were not supportive, and only 2.4% were highly negative. This suggests that personal capability or lack of family support do not inhibit women’s success in these fields.
Over two thirds of all respondents agreed that patriarchal attitudes are significant. Discrimination against women in securing decision making positions, hegemonic masculinity perpetuated by socio-cultural values and beliefs affect women’s ability to succeed. So too do organisational perceptions of gender inequality among both men and women.
Nearly 80% reported that women faced obstacles in the work environment that men did not, and that 63% percent constantly needed to prove themselves to be as capable as men.
Policies to address the gender gap in science, technology, engineering and mathematics do exist. But, they are rarely implemented and where they are, many reflect society’s undervaluing of women in the workplace.
Implementation of these policies should be supported by laws to ensure proper representation. Achieving parity (50:50 ratio of female to male) is important to balance and increase the numbers of women while promoting equity. This refers to fairness of treatment for women and men and also takes into consideration the different gender needs, obligations and opportunities.
The findings were also that recruitment and promotion practices and gender relations at work play a great role in determining women’s success. Even though 90% of the respondents agreed that they were recruited on merit, only about 57% said they were sufficiently rewarded, based on their qualifications. They also had fewer career opportunities than men.
Next steps
A gendered lens is certainly important in achieving the Sustainable Development Goals of ending poverty, protecting the planet and ensuring peace and prosperity for all by 2030. It’s just as important in achieving the African Union’s agenda of having peace and prosperity on the continent by 2063. The African Academy of Sciences has a vision to transform African lives through science. Our study highlights the importance of role modelling in growing the visibility and expert voice of women in science, technology, engineering and mathematics. None of these objectives can be achieved if women, who are half the population, are left out.
Although it may take a while to change societal factors that affect the ability of African women to succeed in these fields, and to have their voices heard, such a change will not happen without deliberate intervention. Efforts such as this, that increase the awareness about scientific analyses by women and the visibility of women in these fields, are to be encouraged. A concerted effort to enable “the podium” equitably would be a first step towards reaping the benefit of that, much needed, diversity of perspectives.
AESA is a partnership of the African Academy of Sciences and the African Union Development Agency. The study was supported by IAVI.
For more on the original article visit: https://theconversation.com/study-sheds-light-on-what-it-takes-for-women-to-succeed-or-not-in-science-in-africa-147921